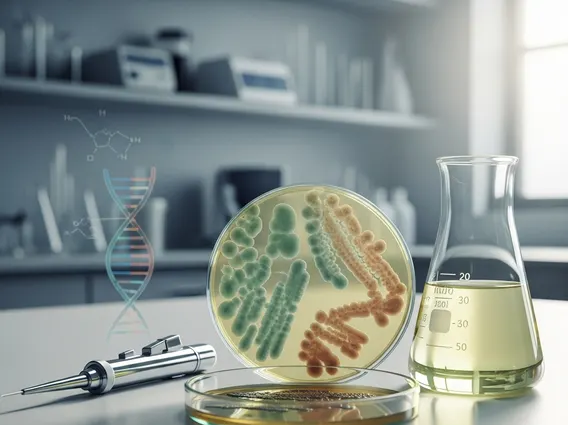

Prebiotics: Feeding Healthy Gut Bacteria
In the quest for optimal health, the spotlight often falls on the gut, a complex ecosystem teeming with trillions of microorganisms. Among the key players in maintaining this delicate balance are prebiotics for gut health, non-digestible fibers that serve as nourishment for beneficial bacteria. Understanding their role is crucial for anyone looking to enhance their digestive wellness and overall well-being.
Key Takeaways
- Prebiotics are specialized plant fibers that selectively feed beneficial bacteria in the gut.
- They are crucial for maintaining a diverse and healthy gut microbiome, which supports digestion, immunity, and nutrient absorption.
- Many common foods, including fruits, vegetables, and whole grains, are excellent natural sources of prebiotics for gut health.
- Prebiotics vs probiotics for digestion highlights their distinct yet complementary roles: prebiotics feed, while probiotics introduce live beneficial bacteria.
- Regular intake of prebiotics can significantly contribute to improved digestive function and overall systemic health.
Understanding Prebiotics and Their Benefits
What are prebiotics and their benefits? Prebiotics are a type of dietary fiber that the human body cannot digest. Instead, they pass through the upper gastrointestinal tract undigested and reach the large intestine, where they are fermented by beneficial gut bacteria. This fermentation process is vital, as it produces short-chain fatty acids (SCFAs) like butyrate, acetate, and propionate, which are crucial for gut health and have far-reaching systemic effects.
The primary mechanism by which prebiotics exert their positive influence is by selectively stimulating the growth and activity of specific beneficial bacteria, such as Bifidobacteria and Lactobacilli. This explains how prebiotics feed healthy gut bacteria, essentially acting as a fertilizer for the good microbes already residing in your digestive system. By promoting a thriving population of these beneficial bacteria, prebiotics help to crowd out harmful pathogens, maintain the integrity of the gut lining, and support a balanced immune response. The importance of prebiotics for gut microbiome cannot be overstated, as a diverse and robust microbiome is linked to improved digestion, nutrient absorption, and even mood regulation.
Beyond their direct impact on gut flora, the benefits of prebiotics extend to various aspects of health. Regular consumption has been associated with improved bowel regularity, enhanced mineral absorption (particularly calcium and magnesium), and a reduction in inflammation. Furthermore, a healthy gut microbiome, supported by prebiotics, plays a significant role in immune function. Research indicates that a substantial portion of the body’s immune cells reside in the gut, making gut health a cornerstone of overall immunity. According to the National Institute of Diabetes and Digestive and Kidney Diseases (NIDDK), digestive diseases affect an estimated 60 to 70 million people in the United States, underscoring the critical need for dietary interventions like prebiotics to support digestive wellness.
Foods Rich in Prebiotics for Gut Health
Incorporating foods rich in prebiotics for gut health into your daily diet is a practical and effective way to nourish your beneficial gut bacteria. Many common fruits, vegetables, and grains are excellent natural sources of prebiotics for gut health, making it easy to boost your intake through whole foods rather than relying solely on supplements. These foods contain various types of prebiotic fibers, such as inulin, fructans, galactooligosaccharides (GOS), and resistant starch, each contributing uniquely to the gut ecosystem.
A diverse diet rich in plant-based foods is key to ensuring you consume a wide spectrum of prebiotics. Aim to include a variety of these foods regularly to provide comprehensive support for your gut microbiome. Gradual introduction of prebiotic-rich foods is often recommended to allow the digestive system to adjust, minimizing potential discomfort such as gas or bloating.
Common Prebiotic-Rich Vegetables and Fruits
Many everyday produce items are packed with the fibers your gut bacteria love. These are easy to integrate into meals and snacks:
- Garlic: Contains fructans, which support the growth of beneficial Bifidobacteria.
- Onions: Rich in inulin and fructooligosaccharides (FOS), promoting a healthy gut environment.
- Leeks: Similar to onions and garlic, leeks are excellent sources of prebiotic fibers.
- Asparagus: Contains inulin, known for its ability to stimulate beneficial gut bacteria.
- Bananas (slightly green): Contain resistant starch, which acts as a prebiotic.
- Apples: Pectin, a type of fiber found in apples, has prebiotic effects.
- Dandelion Greens: A potent source of inulin, great for salads or cooking.
Grains and Legumes as Prebiotic Sources
Beyond fruits and vegetables, several grains and legumes offer substantial prebiotic benefits, contributing to a well-rounded diet for gut health:
- Oats: Contain beta-glucan, a soluble fiber with prebiotic properties.
- Barley: Another grain rich in beta-glucan and other beneficial fibers.
- Legumes (e.g., lentils, chickpeas, beans): Excellent sources of resistant starch and galactooligosaccharides (GOS).
- Whole Wheat: Contains arabinoxylan, a fiber that can enhance gut microbial diversity.
Prebiotics vs. Probiotics: Key Differences
The terms prebiotics and probiotics are often used interchangeably, but they refer to distinct components that play complementary roles in digestive health. Understanding prebiotics vs probiotics for digestion is essential for a comprehensive approach to gut wellness. While both contribute to a healthy gut, their mechanisms of action are fundamentally different. Prebiotics are non-digestible food ingredients that selectively stimulate the growth and activity of beneficial microorganisms already present in the colon. They are essentially the “food” for your good gut bacteria.
Probiotics, on the other hand, are live microorganisms that, when administered in adequate amounts, confer a health benefit on the host. These are the “good bacteria” themselves, introduced into the gut to supplement or enhance the existing microbial population. Common sources of probiotics include fermented foods like yogurt, kefir, sauerkraut, and kimchi, as well as dietary supplements. While prebiotics nourish the existing beneficial bacteria, probiotics introduce new beneficial strains, working together to create a robust and balanced gut microbiome.
The synergy between prebiotics and probiotics is often referred to as synbiotic. When combined, prebiotics can enhance the survival and activity of probiotic strains, leading to more pronounced health benefits. For example, consuming yogurt (a probiotic source) with a banana (a prebiotic source) can create a synbiotic effect, maximizing the positive impact on your digestive system. Both are vital for maintaining optimal gut health, with prebiotics fostering the growth of indigenous beneficial bacteria and probiotics introducing new ones to diversify the microbial community.
| Feature | Prebiotics | Probiotics |
|---|---|---|
| Nature | Non-digestible fibers (food for bacteria) | Live beneficial microorganisms (bacteria, yeasts) |
| Role | Feed and stimulate growth of existing beneficial gut bacteria | Introduce new beneficial bacteria to the gut |
| Sources | Fiber-rich foods (garlic, onions, oats, bananas, legumes) | Fermented foods (yogurt, kefir, sauerkraut, kimchi), supplements |
| Mechanism | Fermented by gut bacteria, producing beneficial SCFAs | Colonize the gut, compete with pathogens, produce beneficial compounds |
| Key Benefit | Enhance gut microbiome diversity and activity | Replenish and diversify gut flora, support digestion and immunity |
Frequently Asked Questions
Here are answers to some common questions about prebiotics:
How quickly do prebiotics work?
The effects of prebiotics can vary among individuals, but many people may start to notice improvements in digestive regularity and comfort within a few days to a couple of weeks of consistent intake. The changes in the gut microbiome itself, such as increased populations of beneficial bacteria, can begin relatively quickly, often within days. However, the full range of systemic health benefits, like enhanced immune function or mineral absorption, typically takes longer to manifest, requiring sustained dietary changes over several weeks or months.
Can prebiotics cause side effects?
When first introducing prebiotics into the diet, some individuals may experience mild digestive side effects such as gas, bloating, or abdominal discomfort. This is often due to the fermentation process occurring in the gut and typically subsides as the digestive system adjusts. To minimize these effects, it’s recommended to start with small amounts of prebiotic-rich foods and gradually increase intake over time. If severe or persistent symptoms occur, it is advisable to consult a healthcare professional.
Are prebiotic supplements necessary?
For most healthy individuals, obtaining sufficient prebiotics through a balanced diet rich in fruits, vegetables, whole grains, and legumes is entirely achievable and often preferred. Whole foods provide a complex array of nutrients and fibers that work synergistically. Prebiotic supplements may be beneficial for individuals with specific dietary restrictions, those struggling to meet their fiber needs through diet alone, or under the guidance of a healthcare provider for targeted therapeutic purposes. Always prioritize whole food sources first.